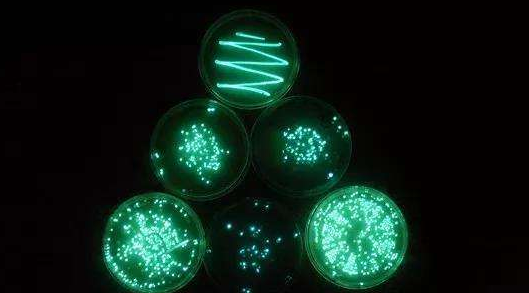
图片5.png

发光菌的“冷”知识
郭文浚/研发中心
水质污染现状
在21世纪飞速发展的当下,工农业废水排放的种类和数量都大幅度增加,水质问题已经成为了一个不容忽视的环保重点。废水的不合理排放最终都会通过富集等方式,经由生态循环对水生动物以外的生物造成影响,更不用说通过最常见的饮用水影响生物了。废水成分日益复杂,传统的化学检测手段已经不能完全满足市场对水质检测的要求了。在考察和监督过程中,快速检测水质中毒物的联合效应往往比检测出每种成分是否超标更重要。这种时候,生物毒性检测手段就可以很好的满足这种检测需求。
常见的生物毒性检测方法有发光菌法、藻类分析法、蚤类分析法和鱼类分析法。快速测试过程中,往往最需要的是便携性,其中,发光菌法不仅能全面快速地反映多种有毒物质的联合效应,更可通过冻干保存等手段制成便携式的菌种,通过简单的干冰运输,以满足便携性的需求。而后三者要实现便携性操作基本都是局限在实验耗时长、操作繁琐和运输复杂等问题上。
发光菌的相关记录
早在亚里士多德的时代,人们就已经发现腐臭的鱼会在黑暗中发出荧光,亚里士多德在《De Anima》一书中就记录了这种情形。我国宋代沈括所著的《异事异疾附》中也记载了臭鸭蛋发光的现象。由于当时的技术限制,人们只能对这些现象进行简单的概括,甚至可能认为是恶魔降临、神明下凡。而实际上,根据资料记载可推断,这些都是发光菌造成的。

发光菌的各种第一次
众所周知,在1683年列文虎克发明了第一台真正意义上的显微镜后,人们才第一次观察到了细菌。然而,发光菌只能在黑暗环境中发出很弱的亮光,在白天或者本身就光线比较强的地方是根本看不到它们发光的;细菌本身又极其微小,单个个体大小都是以微米计,这就导致大多数人看到物体发光也不会考虑这是细菌在发光,也就从认知上限制了人们对发光菌深入研究的可能性。

而且,发光菌虽然可以寄生在某些动物身上,但是主要还是在海里(海水里大片的发光菌使得整片海域闪着绿色的荧光,这就是所谓的“海火”)和海洋动物表面生存。综上所述,除了相关的专业研究人员或者工作人员,极少有人对发光菌的存在有什么认知。直至19世纪,西方近代科学发展起来后,才有人于1854年给出了第一个发光细菌的学名,并从此开启了对于发光细菌的相关研究。

发光菌发光机制
发光菌的发光机制比较简单,可以简单分为两步。第一步,发光菌通过正常代谢合成细菌荧光酶、长链脂肪醛(RCHO)和还原型黄素单核苷酸(FMNH2)。第二步,长链脂肪醛(RCHO)、还原型黄素单核苷酸(FMNH2)和氧气在细菌荧光酶的催化下,发生氧化反应,就产生了光和其他产物(第二步可简单理解为第一步三种产物和氧气相互作用,形成光和其他产物,这个氧化反应几乎不产热,主要产生的能量是光能)。其中,还原型黄素单核苷酸(FMNH2)除了会参与上述氧化反应,还是发光菌最主要的呼吸作用参与底物,与细菌的能量产生有直接关系;同时发光菌的细菌荧光酶一般最适温度是18℃左右,超过37℃即会失活。因此,发光菌整个生命过程中对于外界不利因素非常敏感,在培养过程中也需要尽量避免用操作人员的直接接触。当然,也正是因为这样的敏感,才使得发光菌在毒性检测上有着重要意义。

发光菌在科研上的应用
与小白鼠等较大型的动物不同,发光菌个体小,生长周期短,培养简单快捷易上手,通常一点点菌液已经有百万级的个体数量,在科学研究中足以忽略个体间的差异不计,而与一般的微生物相比,发光菌生老病死可通过光度计或者肉眼迅速识别,不需要特别专业的观察器具(如染色剂和显微镜等,大多数微生物染色剂是对人体有毒害作用的)。这些特性使得发光菌成了科研工作里的新宠儿,如抗生素效价比对、麻醉药和新型材料的毒性检测和免疫能力测定等。
抛开在生物毒性检测和推断生物发展史上的重要意义,对于一般人而言,发光菌的发光机制也有着非比寻常的影响。日常生活中,我们最常用到的光是来自于电灯的,而其主要转换形式是由电在一定条件下转换成光能和热能,其中80%以上都是以热能的形式消耗掉的,而仅有很少的一部分转换为光能(即使节能灯也是一样的,虽然节能灯转换电能为光能的效率可能会更高,或者所需要的电能会更少,但其大部分能量还是主要转换成了热能)。而发光菌就不同了,其发光形式(形成亮光的氧化反应是几乎不放热的反应)主要是冷光,也就是说,仅有很少的一部分能量转换为热能。如何做到将目前常见光源转换为冷光,也是目前生物仿生学研究的一大难题。